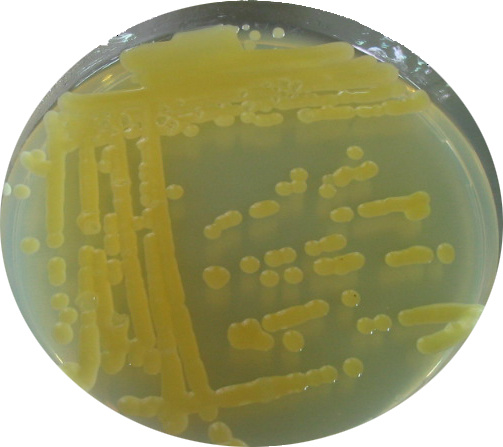
Colonie de bactéries sur milieu nutritif gélosé.

Le portail d'information sur la biodiversité et l'agriculture dans l'océan Indien
|
Contribuer |
Nous contacter
-
Accès thématique
- Abeille
- Agriculture
- Agriculture biologique
- Agriculture de conservation
- Agriculture raisonnée
- Agroécologie
- Aires protégées
- Biodiversité
- Bonnes pratiques
- Changement climatique
- Développement durable
- Ecologie
- Environnement
- Espèces envahissantes
- Fertilisation organique
- Forêt
- Gestion des déchets
- Insulaire
- Intrants chimiques
- Invasion biologique
- Jardin
- Maladies des plantes
- Phytothérapie
- Plantes cultivées/variétés
- Plantes endémiques ou indigènes
- Plantes envahissantes
- Pollinisateurs
- Protection des cultures
- Recherche
- Ressources génétiques
- Ressources naturelles
- Sécurité alimentaire
- Sélection variétale